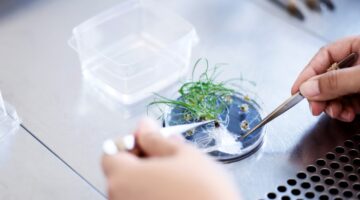

NIB finansierer dansk forskning i græsbioteknologi
F&U afdeling i St Heddinge. Foto: DLF-Trifolium.
Den Nordiske Investeringsbank (NIB) og den danske frøproducent, DLF-Trifolium A/S, har underskrevet en låneaftale på et multi-valuta-lån svarende til EUR 15 millioner med henblik på finansiering af virksomhedens R&D-program fra 2014/2015–2017/2018.
NIBs lån med en løbetid på syv år, vil være med til at finansiere DLF-Trifoliums investeringsprogram de næste fire år, med fokus på planteavl og bioteknologisk innovation. Mange af sorterne er udviklet igennem et omfattende innovationsprogram, specielt med fokus på at forbedre produktiviteten samt modstandskraft mod skadelige sygdomme eller insekter.
DLF-Trifolium er verdens største producent af kløver- og græsfrø, og virksomheden er markedsførende inden for den specialiserede planteavlssektor for tempererede græsarter. Virksomheden samarbejder aktivt med universiteter og forskningsinstitutioner i Danmark og i udlandet og udvikler sin teknologiplatform ved at udveksle kompetencer og viden på tværs af discipliner.
DLF-Trifolium er baseret i Danmark, og virksomheden ejes af danske frøavlere. DLF-Trifolium beskæftiger 800 medarbejdere i tretten lande.
NIB er en international finansieringsinstitution, der ejes af otte medlemslande: Danmark, Estland, Finland, Island, Letland, Litauen, Norge og Sverige. Banken finansierer private og offentlige investeringsprojekter i og uden for medlemslandene. NIB har den højest mulige kreditvurdering, AAA/Aaa, hos de førende kreditvurderingsinstitutter Standard & Poor’s og Moody’s.
For yderligere information kontakt venligst
Vagn Lundhøj, Senior Manager Origination, på tlf.: +358 10 618 0370,
Niina Rantti, Communications Officer, på tlf.: +358 10 618 0265,
